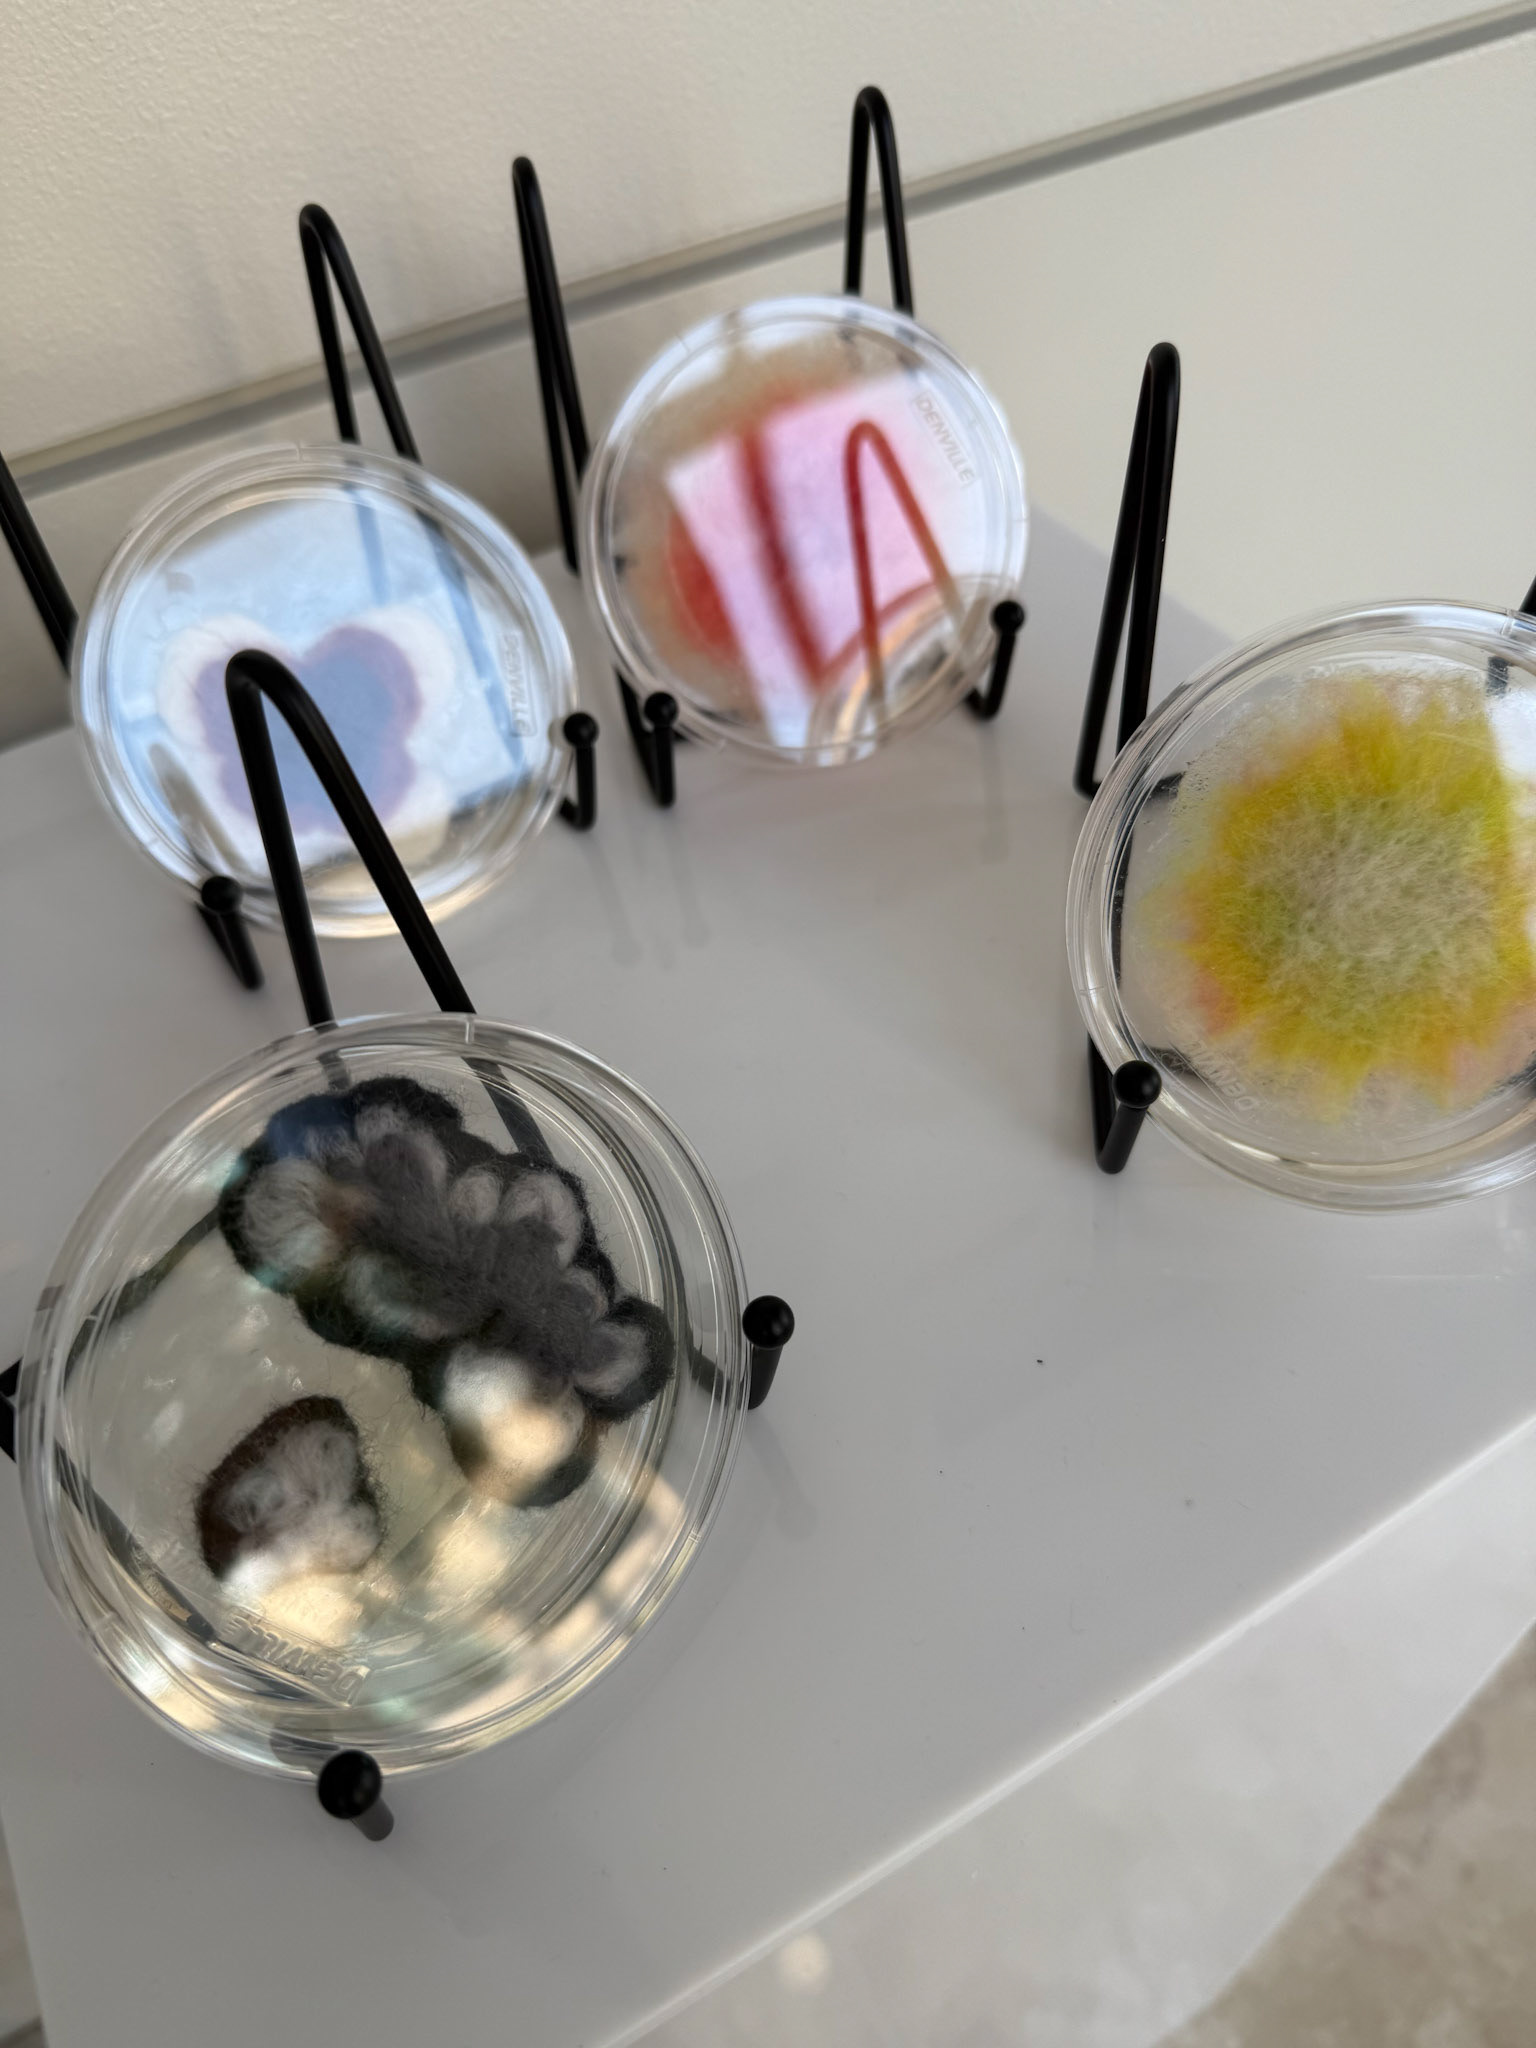

John D. Wiley Gallery for Art in Science
Inaugural Gallery Exhibition Opening Reception September 2025

John D. Wiley

Tamara McLean, Resonance: Deep Time and the Anthropocene, 2025 1/1 Mirrored Glass, wood, ink, 30" round

Augmented Reality 8th Wall interactive experience triggered by art.
"Portal of Discovery" Resonance: Deep Time and the Anthropocene
Resonance: Deep Time and the Anthropocene is an immersive, site-specific augmented reality installation that explores humanity's intersection with geological deep time and environmental stewardship. This artwork engages the public with the concept of "deep time" to provoke reflection on our species' role in the Anthropocene epoch.
On display now, this 8th Wall web browser interactive augmented reality experience is launched by pointing a mobile device camera at the mirror art on the wall.
For more information regarding CHE, please visit: che.nelson.wisc.edu
